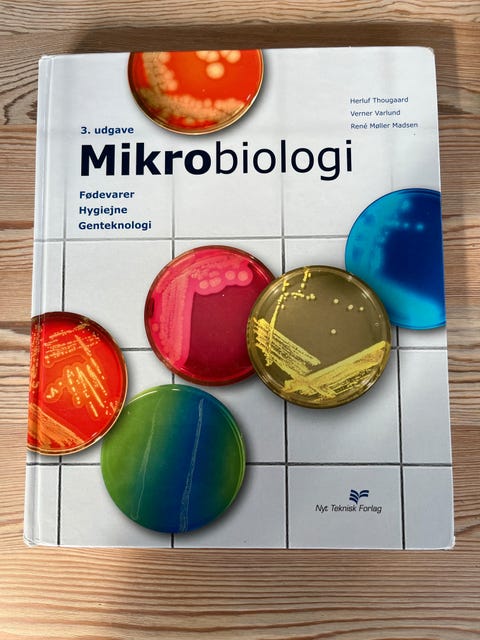

Indholdet er beskyttet i henhold til ophavsretsloven. Regelmæssig, systematisk eller kontinuerlig indsamling, opbevaring og enhver anden form for kompilering af data er ikke tilladt uden udtrykkelig skriftlig tilladelse fra DBA.dk.
© 2009–2025 DBA.dk